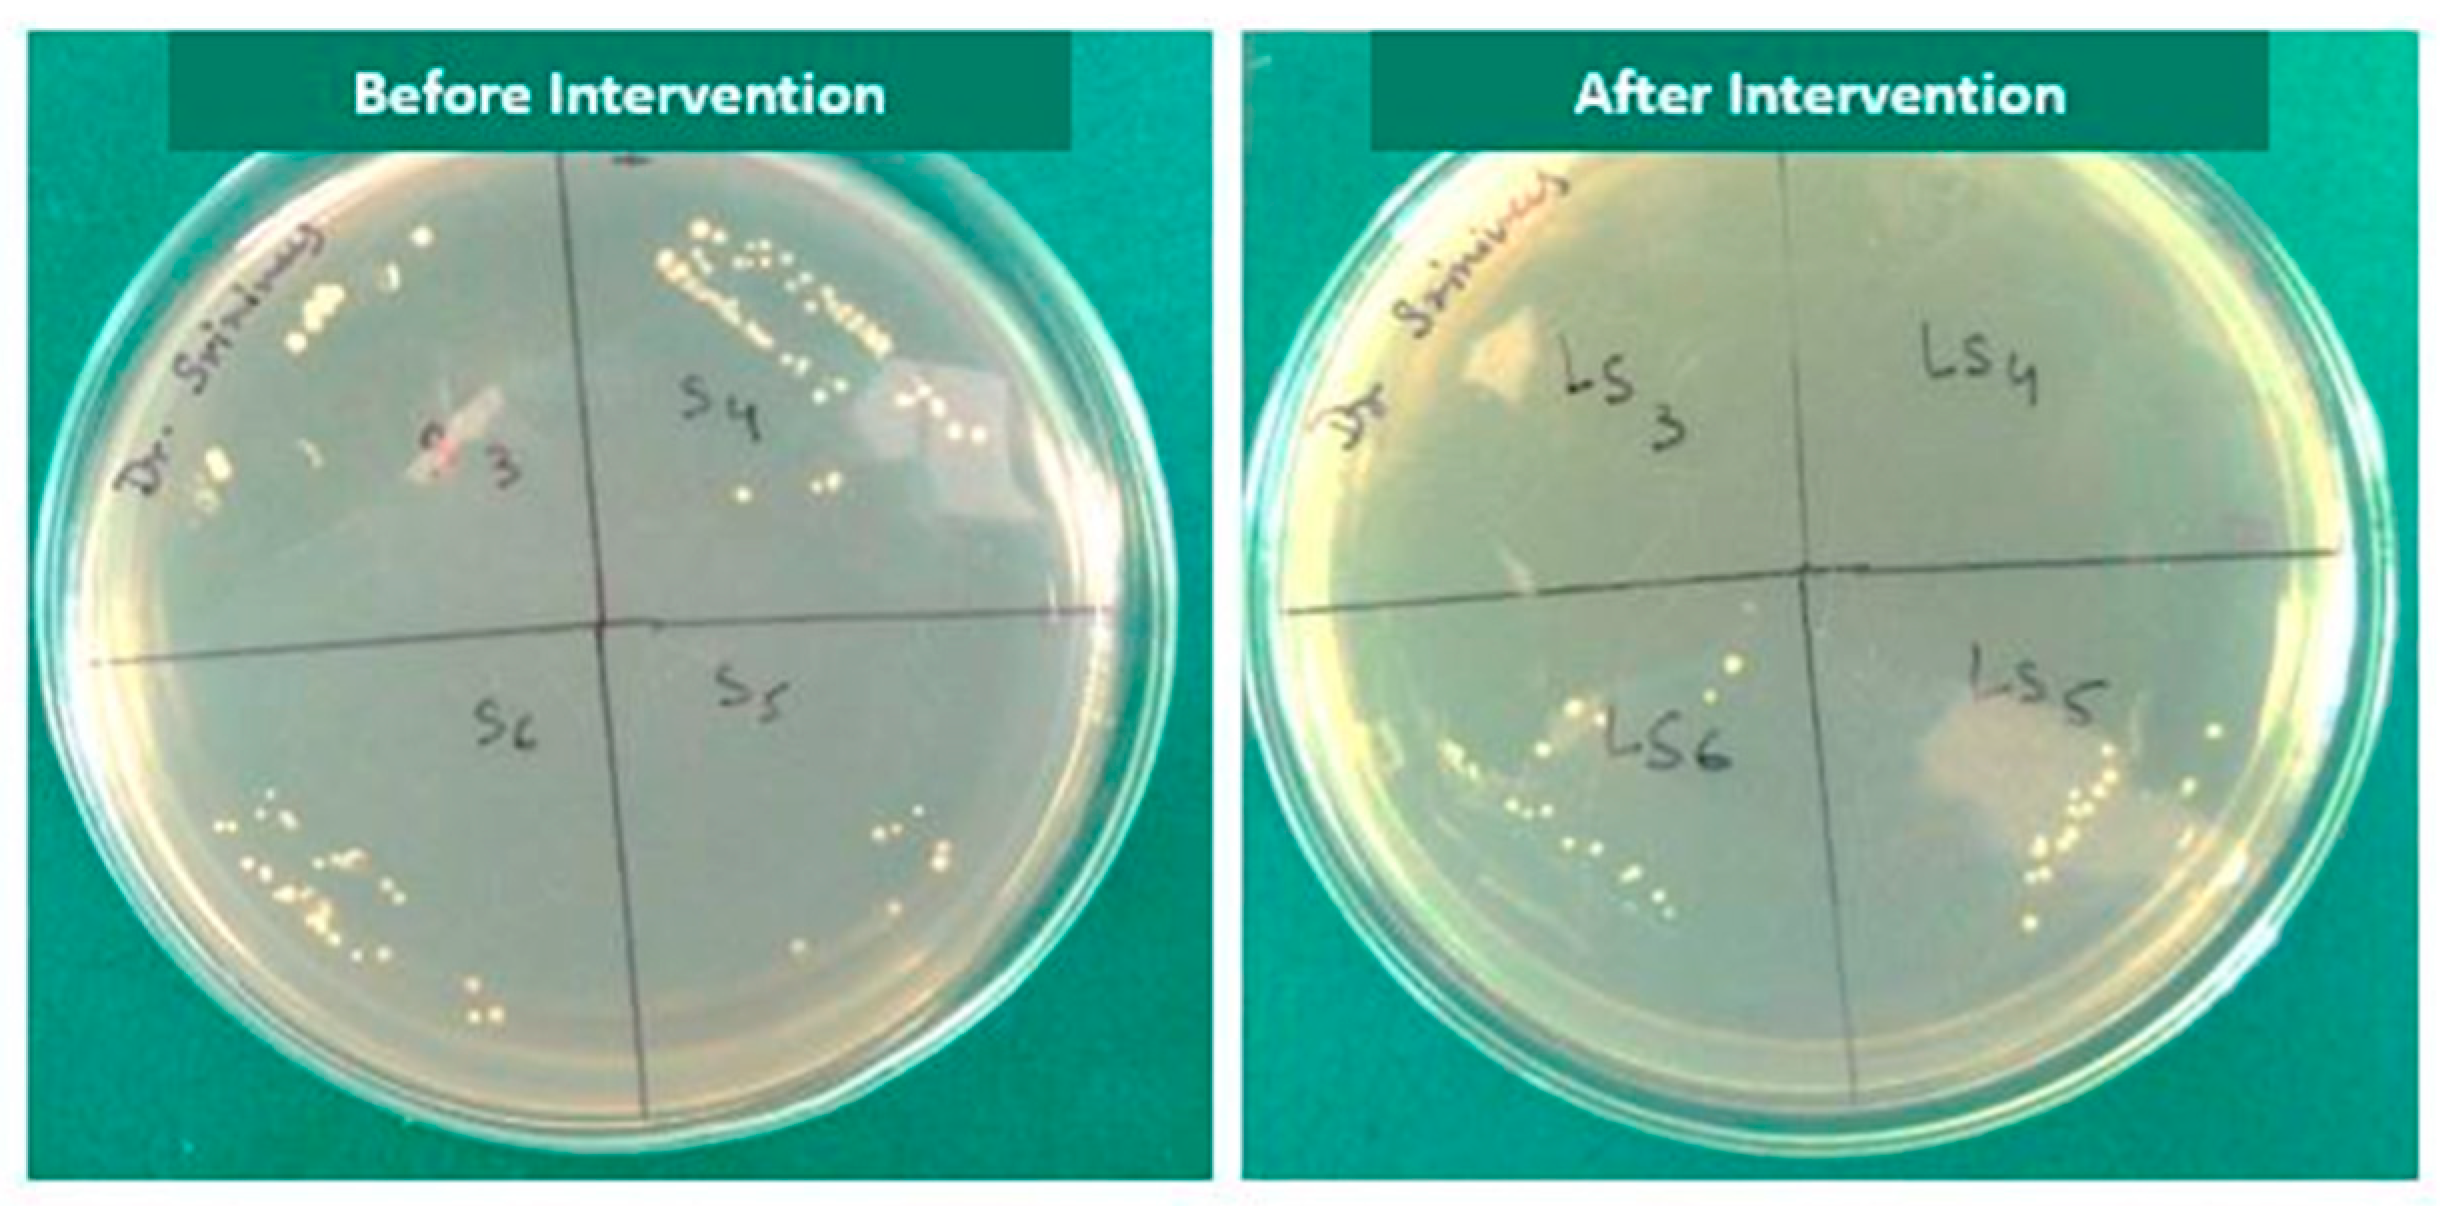
Children 10 01887 g003

Disinfection Efficacy of Laser Activation on Different Forms and Concentrations of Sodium Hypochlorite Root Canal Irrigant against Enterococcus faecalis in Primary Teeth
Abstract
:1. Introduction
2. Materials and Methods
2.1. Study Design (Figure 1)
2.1.1. Inclusion and Exclusion Criteria
- -
- At least two thirds of root length developed.
- -
- Single-rooted and multi-rooted teeth.
- -
- Teeth extracted for therapeutic reasons (over-retained primary teeth, teeth causing ectopic eruption, etc.).
- -
- Teeth with no internal or external pathological root resorption.
- -
- Teeth with no internal or external perforation in the furcation area.
- -
- Root resorption extending beyond half of the total root length.
- -
- Obliterated root canals.

2.1.2. Preparation of Teeth Specimen
2.1.3. Bacterial Inoculation
2.1.4. Sample Size Calculation
2.1.5. Randomisation
2.1.6. Interventional Groups
2.2. Baseline Microbial Analysis
2.3. Diode Laser Activation of Irrigants
2.4. Post-Intervention Microbial Analysis
2.5. Statistical Analysis
3. Results
4. Discussion
5. Conclusions
Author Contributions
Funding
Institutional Review Board Statement
Informed Consent Statement
Data Availability Statement
Conflicts of Interest
References
- Walia, V.; Goswami, M.; Mishra, S.; Walia, N.; Sahay, D. Comparative Evaluation of the Efficacy of Chlorhexidine, Sodium Hypochlorite, the Diode Laser and Saline in Reducing the Microbial Count in Primary Teeth Root Canals–An In Vivo Study. J. Lasers Med. Sci. 2019, 10, 268. [Google Scholar] [CrossRef]
- Sohrabi, K.; Sooratgar, A.; Zolfagharnasab, K.; Kharazifard, M.J.; Afkhami, F. Antibacterial activity of diode laser and sodium hypochlorite in Enterococcus faecalis-contaminated root canals. Iran. Endod. J. 2016, 11, 8. [Google Scholar] [PubMed]
- Roshdy, N.N.; Kataia, E.M.; Helmy, N.A. Assessment of antibacterial activity of 2.5% NaOCl, Chitosan nano-particles against Enterococcus faecalis contaminating root canals with and without diode laser irradiation: An in vitro study. Acta Odontol. Scand. 2019, 77, 39–43. [Google Scholar] [CrossRef] [PubMed]
- Öter, B.; Topcuoglu, N.; Tank, M.K.; Cehreli, S.B. Evaluation of antibacterial efficiency of different root canal disinfection techniques in primary teeth. Photomed. Laser Surg. 2018, 36, 179–184. [Google Scholar] [CrossRef] [PubMed]
- Haapasalo, H.K.; Siren, E.K.; Waltimo, T.M.; Orstavik, D.; Haapasalo, M.P. Inactivation of local root canal medicaments by dentine- an in vitro study. Int. Endod. J. 2000, 33, 126–131. [Google Scholar] [CrossRef] [PubMed]
- Nesser, S.F.A.; Bshara, N.G. Evaluation of the apical extrusion of sodium hypochlorite gel in immature permanent teeth: An in vitro study. Dent. Med. Probl. 2019, 56, 149–153. [Google Scholar] [CrossRef] [PubMed]
- de Souza, E.B.; Cai, S.; Simionato, M.R.; Lage-Marques, J.L. High-power diode laser in the disinfection in depth of the root canal dentin. Oral Surg. Oral Med. Oral Pathol. Oral Radiol. Endod. 2008, 106, e68–e72. [Google Scholar] [CrossRef] [PubMed]
- Castelo-Baz, P.; Martín-Biedma, B.; Ruíz-Pinon, M.; Rivas-Mundina, B.; Bahillo, J.; Seoane-Prado, R.; Perez-Estévez, A.; Gude, F.; De Moor, R.; Varela-Patiño, P. Combined sodium hypochlorite and 940 nm diode laser treatment against mature E. faecalis biofilms in-vitro. J. Lasers Med. Sci. 2012, 3, 116–121. [Google Scholar]
- Yavagal, C.M.; Patil, V.C.; Yavagal, P.C.; Kumar, N.K.; Hariharan, M.; Mangalekar, S.B. Efficacy of Laser Photoacoustic Streaming in Paediatric Root Canal Disinfection-An Ex-Vivo Study. Contemp. Clin. Dent. 2021, 12, 44–48. [Google Scholar] [CrossRef]
- Kotecha, N.; Shah, N.C.; Doshi, R.J.; Kishan, K.V.; Luke, A.M.; Shetty, K.P.; Mustafa, M.; Pawar, A.M. Microbiological Effectiveness of Sodium Hypochlorite Gel and Aqueous Solution When Implemented for Root Canal Disinfection in Multirooted Teeth: A Randomized Clinical Study. J. Funct. Biomater. 2023, 14, 240. [Google Scholar] [CrossRef]
- Shamsi, P.N.; Yeganeh, L.A.B.; Saberi, B.V.; Azadeh, K.F.P.; Kashani, T. Antibacterial effect of sodium hypochlorite gel and solution on Enterococcus faecalis. J. Dentomaxillofac. Radiol. Pathol. Surg. 2017, 6, 27–31. [Google Scholar]
- Hasna, A.A.; Da Silva, L.P.; Pelegrini, F.C.; Ferreira, C.L.R.; de Oliveira, L.D.; Carvalho, C.A.T. Effect of sodium hypochlorite solution and gel with/without passive ultrasonic irrigation on Enterococcus faecalis, Escherichia coli and their endotoxins. F1000Research 2020, 9, 642. [Google Scholar] [CrossRef] [PubMed]
- Luz, L.B.; Santana, R.; Prates, A.W.; Froelich, J.; De Melo, T.A.; Montagner, F.; Luisi, S.B. Antimicrobial action, ph, and tissue dissolution capacity of 2.5% sodium hypochlorite gel and solution. J. Health Biol. Sci. 2019, 7, 121–125. [Google Scholar] [CrossRef]
- Zand, V.; Lotfi, M.; Soroush, M.H.; Abdollahi, A.A.; Sadeghi, M.; Mojadadi, A. Antibacterial Efficacy of Different Concentrations of Sodium Hypochlorite Gel and Solution on Enterococcus faecalis Biofilm. Iran. Endod. J. 2016, 11, 315–319. [Google Scholar]
- Karataş, E. Postoperative pain after the use of sodium hypochlorite gel and solution forms: A randomized clinical study. Eur. Endod. J. 2020, 6, 34–37. [Google Scholar] [CrossRef]
- Faria, G.; Viola, K.S.; Coaguila-Llerena, H.; Oliveira, L.R.A.; Leonardo, R.T.; Aranda-García, A.J.; Guerreiro-Tanomaru, J.M. Penetration of sodium hypochlorite into root canal dentine: Effect of surfactants, gel form and passive ultrasonic irrigation. Int. Endod. J. 2019, 52, 385–392. [Google Scholar] [CrossRef]
- Vaid, D.; Shah, N.; Kothari, D.; Bilgi, P. Additive effect of photoactivated disinfection on the antibacterial activity of QMix 2 in 1 against 6-week Enterococcus faecalis biofilms: An in vitro study. J. Conserv. Dent. 2017, 20, 41–45. [Google Scholar] [CrossRef]
- Attiguppe, P.R.; Tewani, K.K.; Naik, S.V.; Yavagal, C.M.; Nadig, B. Comparative Evaluation of Different Modes of Laser Assisted Endodontics in Primary Teeth: An In vitro Study. J. Clin. Diagn. Res. 2017, 11, ZC124–ZC127. [Google Scholar] [CrossRef]
- Dai, S.; Xiao, G.; Dong, N.; Liu, F.; He, S.; Guo, Q. Bactericidal effect of a diode laser on Enterococcus faecalis in human primary teeth—an in vitro study. BMC Oral. Health 2018, 18, 154. [Google Scholar] [CrossRef]
- Mehrvarzfar, P.; Akhavan, H.; Rastgarian, H.; Akhlagi, N.M.; Soleymanpour, R.; Ahmadi, A. An in vitro comparative study on the antimicrobial effects of bioglass 45S5 vs. calcium hydroxide on Enterococcus faecalis. Iran. Endod. J. 2011, 6, 29. [Google Scholar]
- Neelakantan, P.; Cheng, C.Q.; Mohanraj, R.; Sriraman, P.; Subbarao, C.; Sharma, S. Antibiofilm activity of three irrigation protocols activated by ultrasonic, diode laser or Er: YAG laser in vitro. Int. Endod. J. 2015, 48, 602–610. [Google Scholar] [CrossRef] [PubMed]
- Betancourt, P.; Merlos, A.; Sierra, J.M.; Camps-Font, O.; Arnabat-Dominguez, J.; Viñas, M. Effectiveness of low concentration of sodium hypochlorite activated by Er,Cr:YSGG laser against Enterococcus faecalis biofilm. Lasers Med. Sci. 2019, 34, 247–254. [Google Scholar] [CrossRef] [PubMed]
- Aydin, S.A.; Taşdemir, T.; Buruk, C.K.; Çelik, D. Efficacy of Erbium, Chromium-doped Yttrium, Scandium, Gallium and Garnet Laser-activated Irrigation Compared with Passive Ultrasonic Irrigation, Conventional Irrigation, and Photodynamic Therapy against Enterococcus faecalis. J. Contemp. Dent. Pract. 2020, 21, 11–16. [Google Scholar] [CrossRef]
- Christo, J.E.; Zilm, P.S.; Sullivan, T.; Cathro, P.R. Efficacy of low concentrations of sodium hypochlorite and low-powered Er,Cr:YSGG laser activated irrigation against an Enterococcus faecalis biofilm. Int. Endod. J. 2016, 49, 279–286. [Google Scholar] [CrossRef] [PubMed]
- Raducka, M.; Piszko, A.; Piszko, P.J.; Jawor, N.; Dobrzyński, M.; Grzebieluch, W.; Mikulewicz, M.; Skośkiewicz-Malinowska, K. Narrative Review on Methods of Activating Irrigation Liquids for Root Canal Treatment. Appl. Sci. 2023, 13, 7733. [Google Scholar] [CrossRef]
- Ahmed, H.M. Anatomical challenges, electronic working length determination and current developments in root canal preparation of primary molar teeth. Int. Endod. J. 2013, 46, 1011–1022. [Google Scholar] [CrossRef]
- Wong, J.; Manoil, D.; Näsman, P.; Belibasakis, G.N.; Neelakantan, P. Microbiological Aspects of Root Canal Infections and Disinfection Strategies: An Update Review on the Current Knowledge and Challenges. Front. Oral. Health 2021, 2, 672887. [Google Scholar] [CrossRef]
- Dioguardi, M.; Gioia, G.D.; Illuzzi, G.; Laneve, E.; Cocco, A.; Troiano, G. Endodontic irrigants: Different methods to improve efficacy and related problems. Eur. J. Dent. 2018, 12, 459–466. [Google Scholar] [CrossRef]
- Ozlek, E.; Neelakantan, P.; Khan, K.; Cheung, G.S.; Rossi-Fedele, G. Debris extrusion during root canal preparation with nickel-titanium instruments using liquid and gel formulations of sodium hypochlorite in vitro. Aust. Endod. J. 2021, 47, 130–136. [Google Scholar] [CrossRef]
- Naik, R.G.; Raviraj, G.A.; Yavagal, C.M.; Mandroli, P. Diode Lasers for Pediatric Endodontics: State-of-the-Art. J. Dent. Lasers 2017, 11, 7–13. [Google Scholar] [CrossRef]
- Mishra, A.; Koul, M.; Abdullah, A.; Khan, N.; Dhawan, P.; Bhat, A. Comparative Evaluation of Antimicrobial Efficacy of Diode Laser (Continuous Mode), Diode Laser (Pulse Mode), and 5.25% of Sodium Hypochlorite in Disinfection of Root Canal: A Short Study. Int. J. Clin. Pediatr. Dent. 2022, 15, 579–583. [Google Scholar] [PubMed]
- Jambagi, N.; Kore, P.; Dhaded, N.S. Comparison of Antimicrobial Efficacy of Diode Laser, Ultrasonic Activated and Conventional Irrigation with 2.5% NaOCl during RCT: An Interventional Study. J. Contemp. Dent. Pract. 2021, 22, 669–673. [Google Scholar] [PubMed]

| Group | Subgroup | Mean (SD) | Range | Median (Q1–Q3) | Kruskal–Wallis Test | Mann–Whitney U Test | |||
|---|---|---|---|---|---|---|---|---|---|
| p-Value | Saline vs. NaOCl Solution | Saline vs. NaOCl Gel | NaOCl Solution vs. NaOCl Gel | ||||||
| Group A (Control Group) | Pre-Intervention | Saline | 7.609 (0.046) | 7.556–7.663 | 7.607 (7.565–7.656) | 0.22 (NS) | 0.07 (NS) | 0.47 (NS) | 0.47 (NS) |
| NaOCl solution | 7.54 (0.069) | 7.447–7.623 | 7.544 (7.47–7.607) | ||||||
| NaOCl gel | 7.575 (0.096) | 7.462–7.699 | 7.578 (7.473–7.665) | ||||||
| Post Intervention | Saline | 5.276 (0.589) | 4.778–6.301 | 5.05 (4.828–5.8) | 0.01 * | 0.03 * | 0.004 * | 0.21 (NS) | |
| NaOCl solution | 0.984 (2.41) | 0–5.903 | 0 (0–1.476) | ||||||
| NaOCl gel | 2.867 (2.229) | 0–4.602 | 4.151 (0–4.376) | ||||||
| Group B (Experimental group-Laser group) | Pre-Intervention | Saline | 7.593 (0.105) | 7.491–7.778 | 7.556 (7.521–7.677) | 0.93 (NS) | 1.00 (NS) | 0.57 (NS) | 1.00 (NS) |
| NaOCl solution | 7.585 (0.089) | 7.477–7.699 | 7.589 (7.498–7.665) | ||||||
| NaOCl gel | 7.586 (0.043) | 7.544–7.644 | 7.579 (7.544–7.628) | ||||||
| Post Intervention | Saline | 2.889 (2.248) | 0–4.748 | 4.19 (0–4.34) | 0.03 * | 0.09 (NS) | 0.02 * | 0.14 (NS) | |
| NaOCl solution | 0.717 (1.115) | 0–2.301 | 0 (0–2.075) | ||||||
| NaOCl gel | 0 (0) | 0–0 | 0 (0–0) | ||||||
| Subgroup | Group | Pre-Intervention | Post Intervention | Change | Wilcoxon Signed Rank Test | |||||
|---|---|---|---|---|---|---|---|---|---|---|
| Mean (SD) | Range | Median (Q1–Q3) | Mean (SD) | Range | Median (Q1–Q3) | Mean (SD) | % | p-Value | ||
| Saline | Control Group | 7.609 (0.046) | 7.556–7.663 | 7.607 (7.565–7.656) | 5.276 (0.589) | 4.778–6.301 | 5.05 (4.828–5.8) | 2.333 (0.623) | 30.63 (8.06) | 0.03 * |
| Experimental group (Laser group) | 7.593 (0.105) | 7.491–7.778 | 7.556 (7.521–7.677) | 2.889 (2.248) | 0–4.748 | 4.19 (0–4.34) | 4.704 (2.250) | 61.95 (29.65) | 0.03 * | |
| Mann–Whitney U Test | p = 0.38 (NS) | p = 0.004 * | ||||||||
| NaOCl solution | Control Group | 7.54 (0.069) | 7.447–7.623 | 7.544 (7.47–7.607) | 0.984 (2.41) | 0–5.903 | 0 (0–1.476) | 6.556 (2.403) | 86.98 (31.89) | 0.03 * |
| Experimental group (Laser group) | 7.585 (0.089) | 7.477–7.699 | 7.589 (7.498–7.665) | 0.717 (1.115) | 0–2.301 | 0 (0–2.075) | 6.868 (1.110) | 90.56 (14.66) | 0.03 * | |
| Mann–Whitney U Test | p = 0.30 (NS) | p = 0.67 (NS) | ||||||||
| NaOCl gel | Control Group | 7.575 (0.096) | 7.462–7.699 | 7.578 (7.473–7.665) | 2.867 (2.229) | 0–4.602 | 4.151 (0–4.376) | 4.707 (2.295) | 61.93 (29.62) | 0.03 * |
| Experimental group (Laser group) | 7.586 (0.043) | 7.544–7.644 | 7.579 (7.544–7.628) | 0 (0) | 0–0 | 0 (0–0) | 7.586 (0.043) | 100.00 (0.00) | 0.03 * | |
| Mann–Whitney U Test | p = 0.87 (NS) | p = 0.02 * | ||||||||
Disclaimer/Publisher’s Note: The statements, opinions and data contained in all publications are solely those of the individual author(s) and contributor(s) and not of MDPI and/or the editor(s). MDPI and/or the editor(s) disclaim responsibility for any injury to people or property resulting from any ideas, methods, instructions or products referred to in the content. |
© 2023 by the authors. Licensee MDPI, Basel, Switzerland. This article is an open access article distributed under the terms and conditions of the Creative Commons Attribution (CC BY) license (https://creativecommons.org/licenses/by/4.0/).
Share and Cite
Yavagal, C.M.; Subramani, S.K.; Patil, V.C.; Yavagal, P.C.; Talwar, R.P.; Hebbal, M.I.; Saadaldin, S.A.; Eldwakhly, E.; Abdelhafeez, M.M.; Soliman, M. Disinfection Efficacy of Laser Activation on Different Forms and Concentrations of Sodium Hypochlorite Root Canal Irrigant against Enterococcus faecalis in Primary Teeth. Children 2023, 10, 1887. https://doi.org/10.3390/children10121887
Yavagal CM, Subramani SK, Patil VC, Yavagal PC, Talwar RP, Hebbal MI, Saadaldin SA, Eldwakhly E, Abdelhafeez MM, Soliman M. Disinfection Efficacy of Laser Activation on Different Forms and Concentrations of Sodium Hypochlorite Root Canal Irrigant against Enterococcus faecalis in Primary Teeth. Children. 2023; 10(12):1887. https://doi.org/10.3390/children10121887
Chicago/Turabian StyleYavagal, Chandrashekar Murugesh, Srinivas K. Subramani, Viplavi Chavan Patil, Puja C. Yavagal, Ramachandra P. Talwar, Mamata Iranna Hebbal, Selma A. Saadaldin, Elzahraa Eldwakhly, Manal M. Abdelhafeez, and Mai Soliman. 2023. "Disinfection Efficacy of Laser Activation on Different Forms and Concentrations of Sodium Hypochlorite Root Canal Irrigant against Enterococcus faecalis in Primary Teeth" Children 10, no. 12: 1887. https://doi.org/10.3390/children10121887
APA StyleYavagal, C. M., Subramani, S. K., Patil, V. C., Yavagal, P. C., Talwar, R. P., Hebbal, M. I., Saadaldin, S. A., Eldwakhly, E., Abdelhafeez, M. M., & Soliman, M. (2023). Disinfection Efficacy of Laser Activation on Different Forms and Concentrations of Sodium Hypochlorite Root Canal Irrigant against Enterococcus faecalis in Primary Teeth. Children, 10(12), 1887. https://doi.org/10.3390/children10121887

